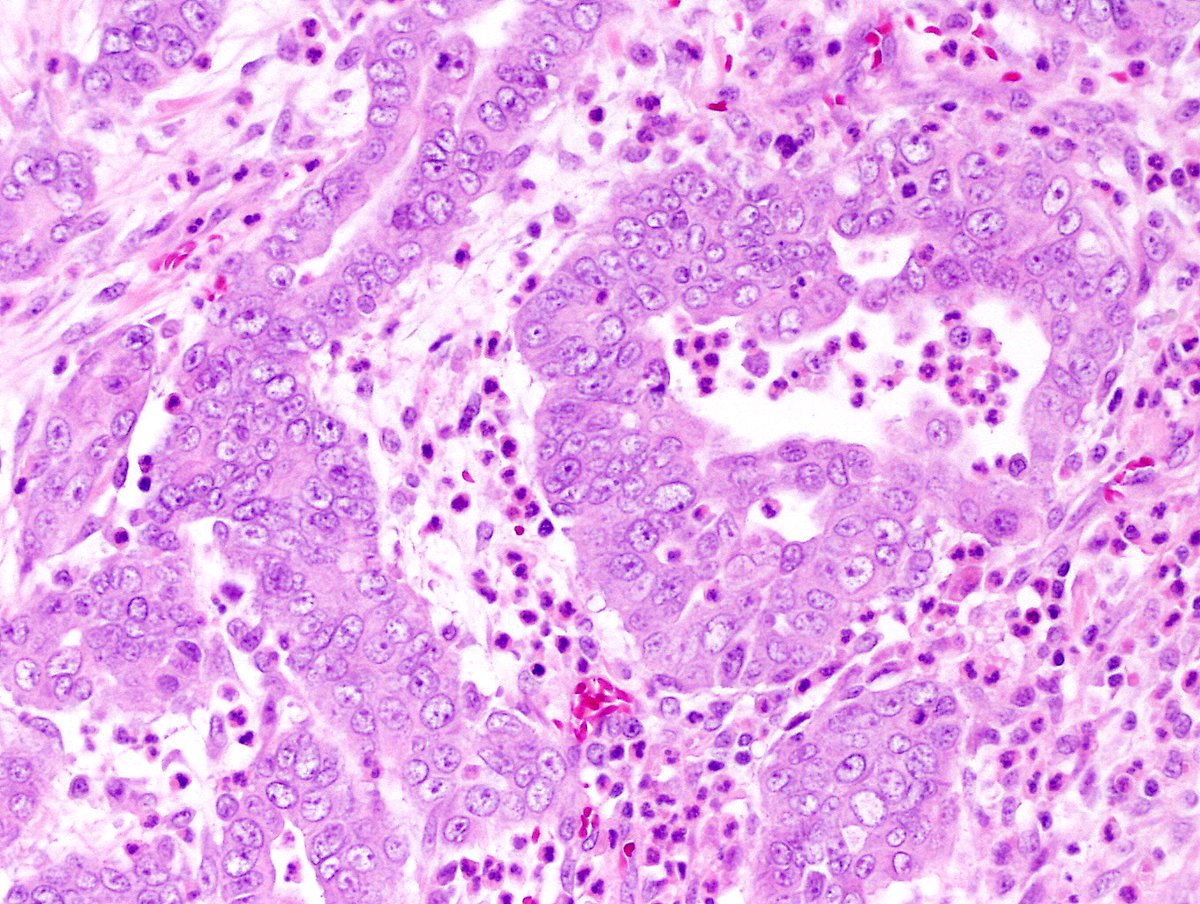
Andres_Matoso's tweet image. Renal Medullary Carcinoma (RMC): highly aggressive tumor in patients with sickle cell trait.
🔬 Infiltrative growth with tubuloreticular and gland-like structures. Pleomorphic nuclei w/ prominent nucleoli. Brisk inflam infiltrate. Associated w/ necrosis and loss of SMARCB1/INI1
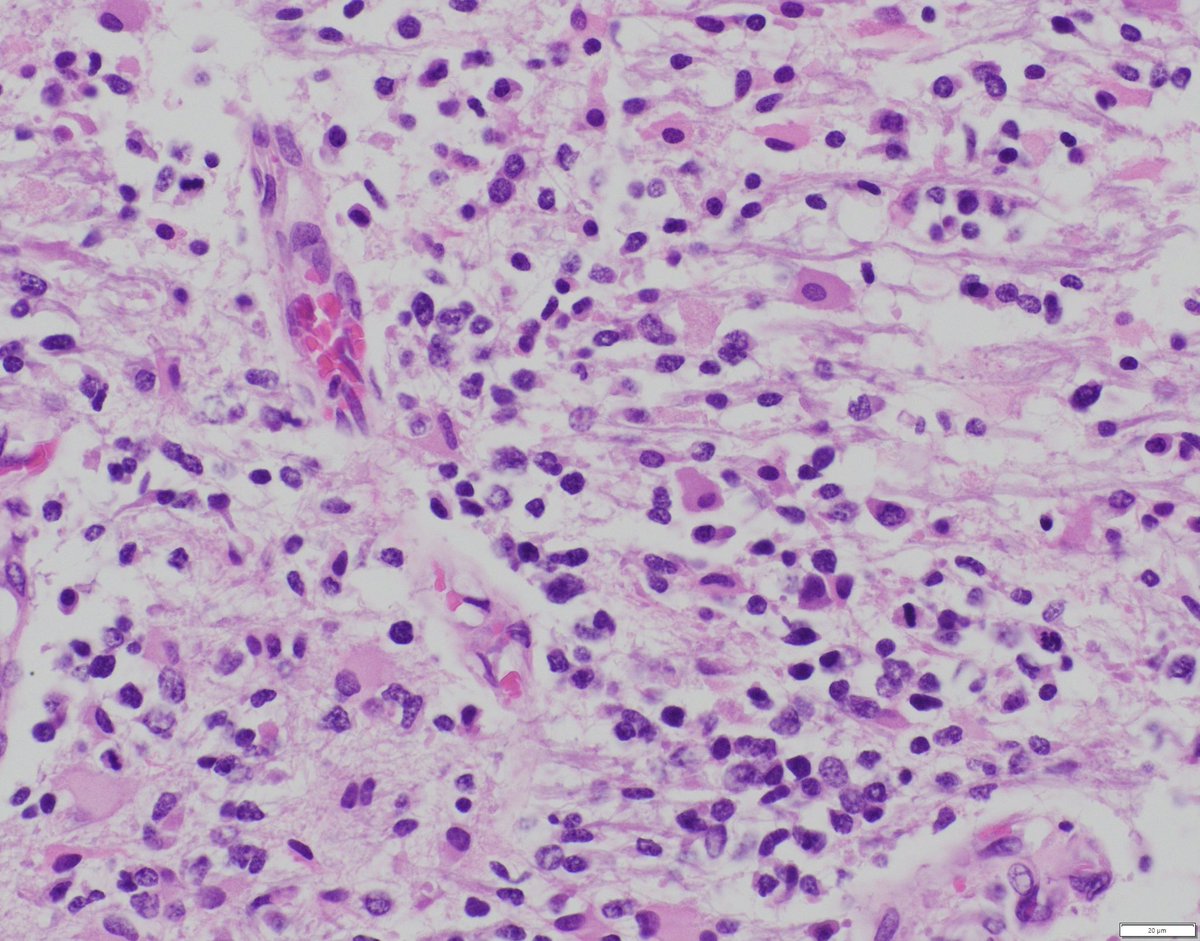
bitar_mireille's tweet image. Diffuse midline #glioma H3 K27-altered WHO grade 4. Diagnostic criteria for subtypes:
-K27M mutation in one of the H3 isoforms
- Overexpression of EZHIP (H3-wt)
- EGFR mutation or amplification
-Methylation profile of one of the subtypes 
#pedipath #neuropath #pathology

#pedipath search results
#PathQuiz 🔬 A) Pleuropulmonary Blastoma B) Rhabdomyosarcoma C) Synovial Sarcoma D) Fetal Lung Interstitial Tumor #Pathology #PediPath 👶 #ThoracicPath

Part 1 of 2: This is a ___ cyst A) thymic B) branchial cleft C) thyroglossal duct D) dermoid 🔬dpa-dapa.com/public/display… #PediPath #PathTitter #Pathology #BSTPath #DermPath

#PathQuiz 🔬🔬 #GUPath A) Rhabdomyosarcoma B) Diffuse Large B-cell Lymphoma C) Clear Cell Sarcoma of the Kidney D) Desmoplastic Small Round Cell Tumor #Pathology #GUPath

Counting eos is not enough 🔍 15 eos/hpf supports EoE, but EoE-HSS captures true disease activity by scoring 8 histologic features. See for yourself: cchmc.pathpresenter.net/public/display… #PediPath #GIpath #EoE #MedEd




Lung #PediPath Developmental lung disease spectrum Dr. Wikenheiser-Brokamp #USCAP25 #pathology #PathX

5 yo girl with foot mass. Answer ✅ youtu.be/W5w_WQAs6HE?si… Digital slide: kikoxp.com/posts/8194. IHC: kikoxp.com/posts/8193. How to tell apart from its “name-alike”: youtu.be/RLyYnaTuxR8?si… #pedipath #BSTpath #pathologists #pathology #pathTwitter #pedsTwitter

Baby girl with a paratracheal cyst arising from a: A) malformation of the tracheobronchial tree B) abnormal sequestration of ectoderm C) failure of branchial cleft obliteration D) failure of thyroglossal duct obliteration #PediPath #PathTwitter #Pathology #BSTPath

More the the bladder/kidney fascicle (arppress.org/books/book/45): Nephroblastoma (Wilms tumor) is a malignant embryonal neoplasm and the most common pediatric renal neoplasm, classically composed of blastemal, stromal, and epithelial elements. #GUpath #pedipath


🔬 Molar Pregnancy ~ Trophoblastic cell proliferation around a villous from a complete hydatidiform mole ~ #GYNpath #PediPath #Pathology

#PathQuiz 🔬 A) Lipoblastoma B) Myofibroma C) Low-grade myofibroblastic sarcoma D) Infantile Fibrosarcoma #Pathology #PediPath #SoftTissuePath

You gross 🔪 a placenta 🩸 And you find this incidental lesion Is it a Chorangioma Chorangiomatosis OR Chorangiosis ?😵💫 #pedipath #peds #pathx #placenta #obgyn



📣Calling all aspiring pediatric pathologists! The #pedipath division at @LurieChildrens is now accepting applications for its 2024-2025 fellowship program. Learn more about the program on our site here: bit.ly/3KfLEt0

#LabWeek Recap! What a great Lab Week! Thank you to everyone who participated and helped make the week so special. We truly appreciate our lab heroes and all that you do every day! #cincinnati_childrens #PediPath #GraduateMedicalEducation #fellowship #cincinnati #pathology #GME




Liver, 2 yo female Solid and cystic large lesion Notice the loose connective tissue and epithelial bile ducts arranged in lobulated islands and also the lymphangioma-like spaces. Diagnosis: Mesenchymal hamartoma #liver #hepatic #PediPath




Newborn Infant 👶 Fever, Irritability, and elevated WBC Umbilical cord surface demonstrates small yellow plaques Dx? 📸 Credit: Robert O Brady, MD #pathx #pedipath #obgyn #peds



Neck Mass; 12yo; It is what it looks like. #HeadandNeckPath #BSTPath #Pedipath @DrGeeONE @JMGardnerMD @DrCycloPath @drlawalm @AishaNabila09 @bjbanji @ariella8 @leon_metlay




History of spine radiation as a child for a CNS neoplasm, few years later with a spinal bone lesion (H&E and p53 IHC).. no osteoid formation seen in the tumor, likely diagnosis? #neuropath #pedipath #molecpath #bonepath


Had so much fun at the Spring SPP meeting! @SocPediPath @BostonChildrens #pediatricpathology #pedipath

5 yo girl with foot mass. Answer ✅ youtu.be/W5w_WQAs6HE?si… Digital slide: kikoxp.com/posts/8194. IHC: kikoxp.com/posts/8193. How to tell apart from its “name-alike”: youtu.be/RLyYnaTuxR8?si… #pedipath #BSTpath #pathologists #pathology #pathTwitter #pedsTwitter

Counting eos is not enough 🔍 15 eos/hpf supports EoE, but EoE-HSS captures true disease activity by scoring 8 histologic features. See for yourself: cchmc.pathpresenter.net/public/display… #PediPath #GIpath #EoE #MedEd




#PathQuiz 🔬🔬 #GUPath A) Rhabdomyosarcoma B) Diffuse Large B-cell Lymphoma C) Clear Cell Sarcoma of the Kidney D) Desmoplastic Small Round Cell Tumor #Pathology #GUPath

✅ Osteofibrous Dysplasia 🎯🦴 • Woven bone trabeculae with prominent osteoblastic rimming within a bland fibrous stroma. • Typically epicentered in the anterior tibial cortex of children, often causing anterior bowing. • Keratin stains highlight only isolated, single cells




#LabWeek Recap! What a great Lab Week! Thank you to everyone who participated and helped make the week so special. We truly appreciate our lab heroes and all that you do every day! #cincinnati_childrens #PediPath #GraduateMedicalEducation #fellowship #cincinnati #pathology #GME




#PathQuiz 🔬🧬 #DermPath A) Langerhans cell histiocytosis B) Juvenile xanthogranuloma C) Mastocytosis D) Rosai-Dorfman disease #Pathology #DermPath


Cyclopia and proboscis, associated with holoprosencephaly. Can be seen in Trisomy 13 but also with normal karyotype. #PediPath
Looks like a myth… but it’s real 💔 fusion of lower limbs & severe internal defects 😱💥 What is the main cause behind this condition?
Yellow-red papule. Forehead of 5yo boy. One pic only. Answer ✅ youtube.com/watch?v=7aso_h… #pathology #pathologists #pathTwitter #dermpath #dermatology #dermatologia #dermtwitter

Our clinical fellow, Dr. Kathryn Rice, presented this morning at the CCHMC Pediatric Grand Rounds – Clinico-Pathological Case (CPC) Conference. We are incredibly proud of our fellows and the outstanding work they continue to do. #cincinnati_childrens #PediPath


It is an honor for me to return to my academic home to share some interesting #PediPath clues to diagnose #CancerPredispositionSyndromes.
🧩 Bladder riddle Unusual location. Think of something more common in children. What’s the diagnosis? 🤔 #DxMindMap #BladderTumor #GUPath #PathTwitter



#PathQuiz 🔬🧬 16-year-old female with a heavily calcified renal mass. History of prior cytotoxic chemotherapy. A) Papillary Renal Cell Carcinoma B) Clear Cell Papillary Renal Cell Tumor C) Fumarate Hydratase-Deficient RCC D) TFE3-rearranged Renal Cell Carcinoma #Pathology

#PathQuiz 🔬 A) Lipoblastoma B) Myofibroma C) Low-grade myofibroblastic sarcoma D) Infantile Fibrosarcoma #Pathology #PediPath #SoftTissuePath

#PathQuiz 🔬 A) Pleuropulmonary Blastoma B) Rhabdomyosarcoma C) Synovial Sarcoma D) Fetal Lung Interstitial Tumor #Pathology #PediPath 👶 #ThoracicPath

Starry sky is also a feature of stress-mediated involution of the thymus in children. #PediPath
#pedipath #liverpath Our comprehensive review on Pathology of Progressive Familial Intrahepatic Cholestasis: An update @PediDevPath journals.sagepub.com/doi/10.1177/10…
journals.sagepub.com
Pathology of Progressive Familial Intrahepatic Cholestasis: An update - Suvradeep Mitra, Mukul Vij,...
Progressive familial intrahepatic cholestasis (PFIC) comprises a heterogeneous group of rare, autosomal recessive liver disorders characterised by defective bil...
Case of the day 🔬 2-year-old male with a bladder mass. Tumor cells show diffuse desmin positivity. Findings are consistent with rhabdomyosarcoma... @IntSocUropath @GU_Path_Society #GUpath #BSTpath


Renal Medullary Carcinoma (RMC): highly aggressive tumor in patients with sickle cell trait. 🔬 Infiltrative growth with tubuloreticular and gland-like structures. Pleomorphic nuclei w/ prominent nucleoli. Brisk inflam infiltrate. Associated w/ necrosis and loss of SMARCB1/INI1

Counting eos is not enough 🔍 15 eos/hpf supports EoE, but EoE-HSS captures true disease activity by scoring 8 histologic features. See for yourself: cchmc.pathpresenter.net/public/display… #PediPath #GIpath #EoE #MedEd




More the the bladder/kidney fascicle (arppress.org/books/book/45): Nephroblastoma (Wilms tumor) is a malignant embryonal neoplasm and the most common pediatric renal neoplasm, classically composed of blastemal, stromal, and epithelial elements. #GUpath #pedipath


Lung #PediPath Developmental lung disease spectrum Dr. Wikenheiser-Brokamp #USCAP25 #pathology #PathX

Intracranial mass in a young patient, which immunostains confirm the diagnosis? #pedipath #neuropath #bonepath #pathology

#PathQuiz 🔬 A) Pleuropulmonary Blastoma B) Rhabdomyosarcoma C) Synovial Sarcoma D) Fetal Lung Interstitial Tumor #Pathology #PediPath 👶 #ThoracicPath

Part 1 of 2: This is a ___ cyst A) thymic B) branchial cleft C) thyroglossal duct D) dermoid 🔬dpa-dapa.com/public/display… #PediPath #PathTitter #Pathology #BSTPath #DermPath

A little mystery for your weekend. Cells in the floor of the intervillous space of a term placenta. There was meconium present. I suspect these are an artifact. x40 #Placenta #PediPath A colleague said I should skip over them, and dubbed them "skipocytes".


Baby girl with a paratracheal cyst arising from a: A) malformation of the tracheobronchial tree B) abnormal sequestration of ectoderm C) failure of branchial cleft obliteration D) failure of thyroglossal duct obliteration #PediPath #PathTwitter #Pathology #BSTPath

Liver, 2 yo female Solid and cystic large lesion Notice the loose connective tissue and epithelial bile ducts arranged in lobulated islands and also the lymphangioma-like spaces. Diagnosis: Mesenchymal hamartoma #liver #hepatic #PediPath




Cystic and solid suprasellar brain mass, what is the likely mutation? #pedipath #neuropath #molecpath

📣Calling all aspiring pediatric pathologists! The #pedipath division at @LurieChildrens is now accepting applications for its 2024-2025 fellowship program. Learn more about the program on our site here: bit.ly/3KfLEt0

Ah, the confusion I still have in placental lesion 😵💫 The perennial question (for me): perivillous fibrin deposition v. infarct Latter look for collapse of the intervillous space and ischemic necrosis (pyknosis, karyorrhexis, loss of nuclear staining) #pathagonia #pedipath



You gross 🔪 a placenta 🩸 And you find this incidental lesion Is it a Chorangioma Chorangiomatosis OR Chorangiosis ?😵💫 #pedipath #peds #pathx #placenta #obgyn



Diffuse midline #glioma H3 K27-altered WHO grade 4. Diagnostic criteria for subtypes: -K27M mutation in one of the H3 isoforms - Overexpression of EZHIP (H3-wt) - EGFR mutation or amplification -Methylation profile of one of the subtypes #pedipath #neuropath #pathology
A puzzle for your weekend. Something doesn't belong. Anyone seen this before? What question would you ask? #Pedipath #Placenta x2, x10, x20, x40




Background brain with cortical dyslamination, thoughts in regard to the abnormal cells? #pedipath #neuropath #path

Newborn Infant 👶 Fever, Irritability, and elevated WBC Umbilical cord surface demonstrates small yellow plaques Dx? 📸 Credit: Robert O Brady, MD #pathx #pedipath #obgyn #peds



Something went wrong.
Something went wrong.
United States Trends
- 1. Resident Evil N/A
- 2. Janet Mills N/A
- 3. Platner N/A
- 4. Zach Cregger N/A
- 5. Good Thursday N/A
- 6. Susan Collins N/A
- 7. Happy Friday Eve N/A
- 8. David Allan Coe N/A
- 9. Amex N/A
- 10. Maine Gov N/A
- 11. Tim Scott N/A
- 12. #MCMRodeadaPorLaMafia N/A
- 13. No Texas N/A
- 14. JP Morgan N/A
- 15. Scalise N/A
- 16. John Wall N/A
- 17. Thirsty Thursday N/A
- 18. Pitch Black N/A
- 19. #ThursdayMotivation N/A
- 20. #lion N/A


































